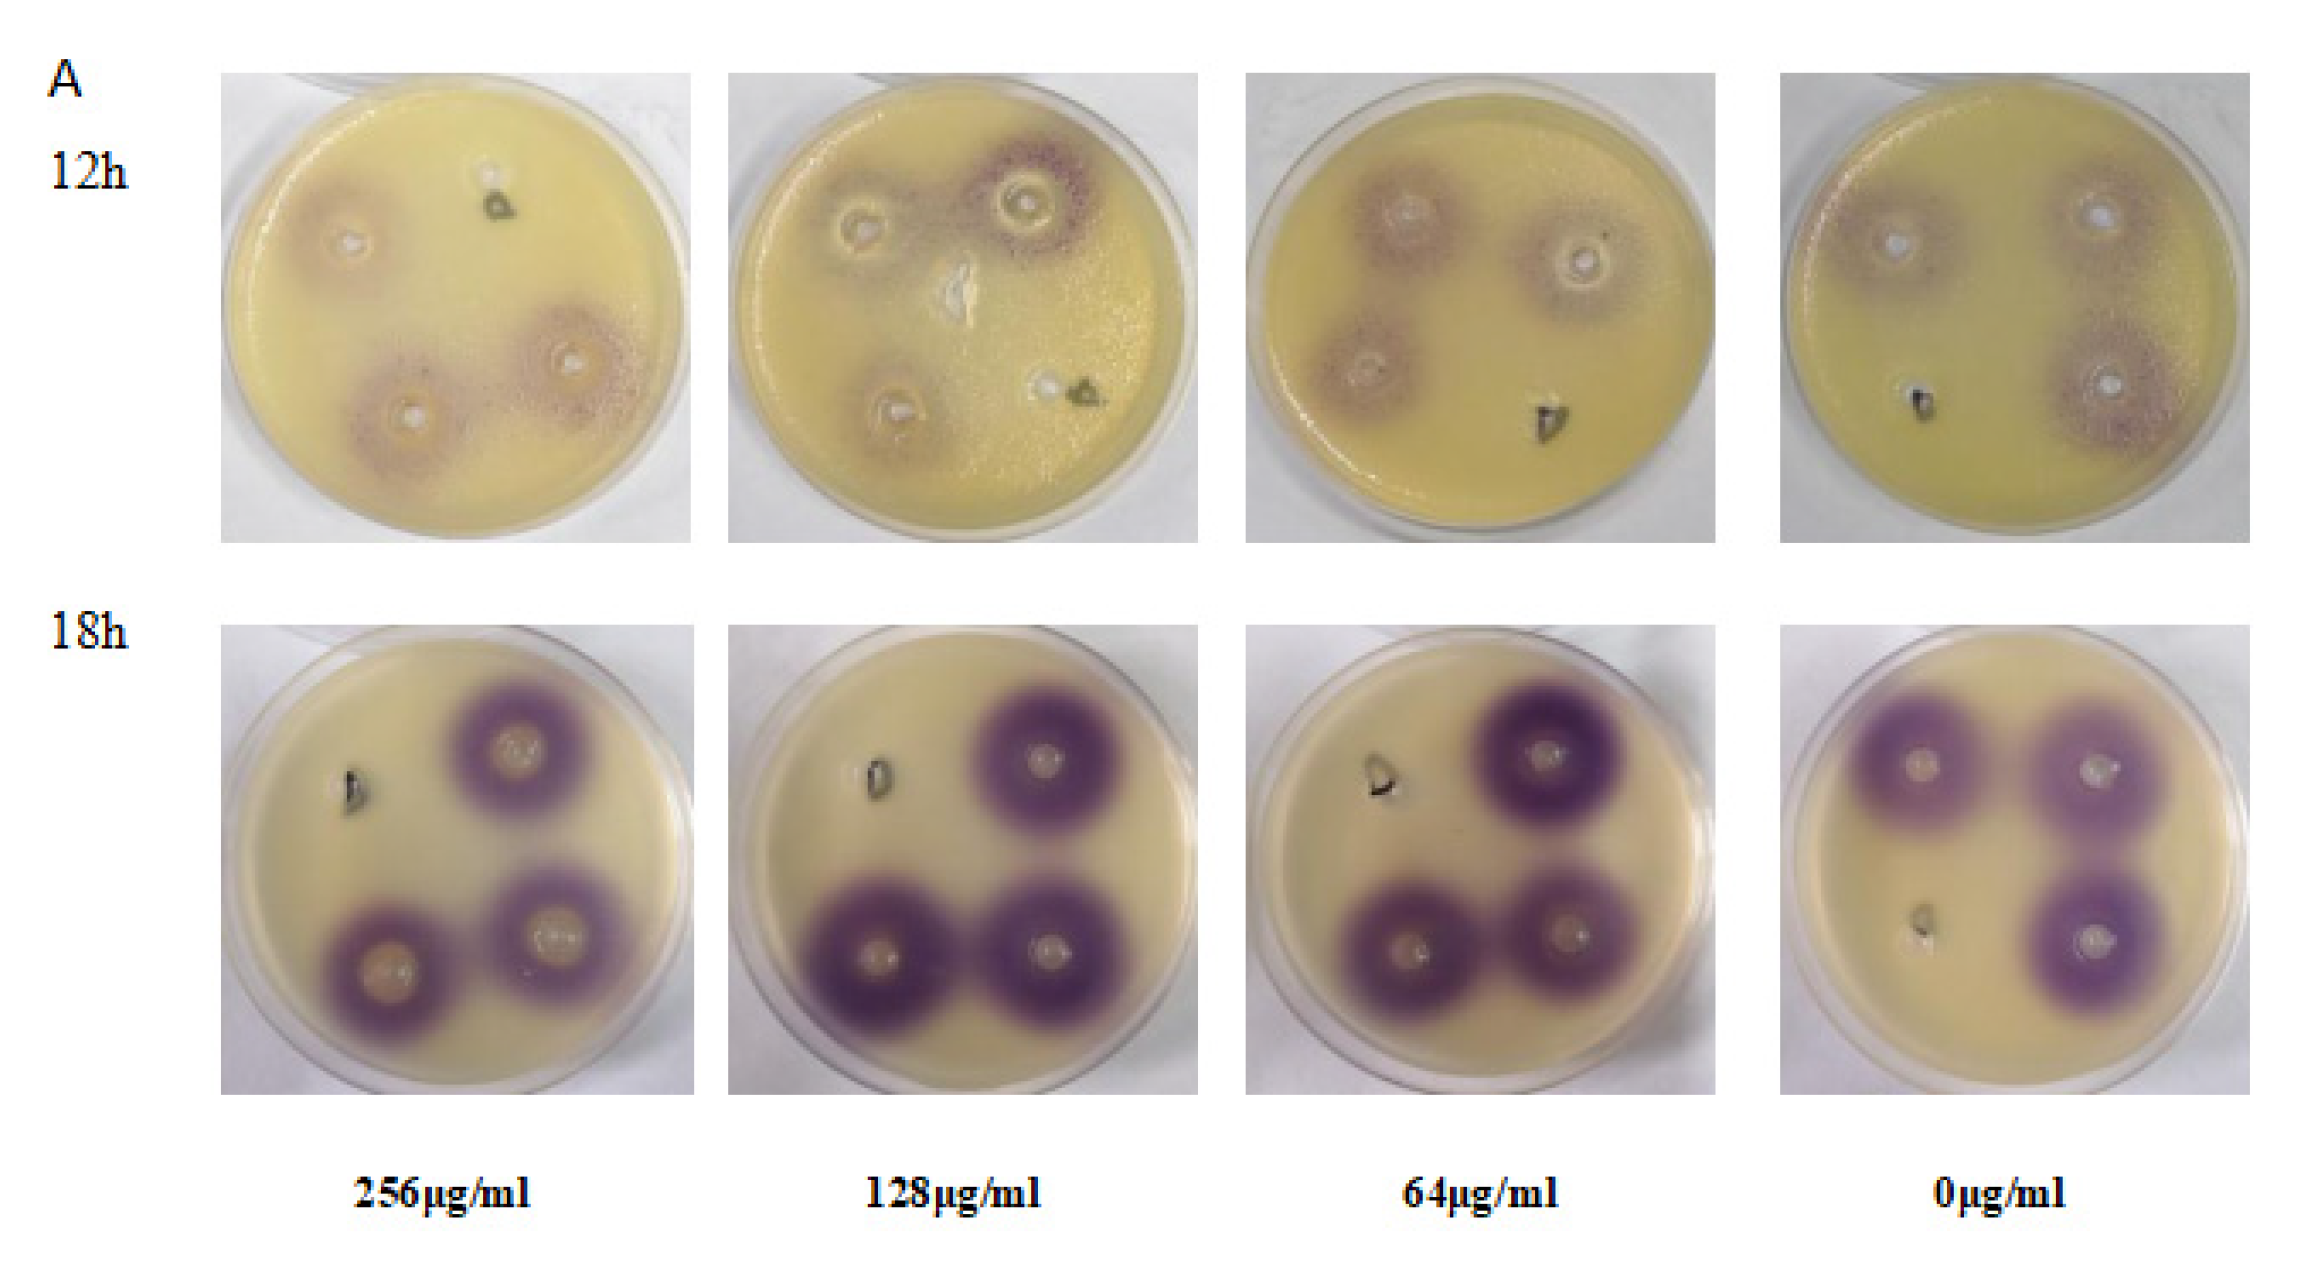

EGCG-Mediated Potential Inhibition of Biofilm Development and Quorum Sensing in Pseudomonas aeruginosa
Abstract
1. Introduction
2. Materials and Methods
2.1. Bacterial Strains, Growth Conditions and Chemicals
2.2. Bioassay for Anti-Quorum Sensing on Solid Broth
2.3. Bioassay for Anti-QS Activity in Liquid Broth
2.4. Determination of Minimum Inhibitory Concentration (MIC) and Growth Curve
2.5. Bacterial Growth Curve Assay
2.6. Biofilm Inhibition Assay
2.7. Quantitation of Extracellular Virulence Factors
2.8. Swimming and Swarming Motility Assays
2.9. Detection of the C4-AHL Molecular Production
2.10. Gene Expression of QS Signal Molecular and Virulence Factors by Quantitative RT-PCR
2.11. Virulence of P. aeruginosa Supernatant Treated by EGCG on C. elegans
2.12. Test the Anti-Infection Activity of EGCG on C. elegans
2.13. Statistical Analysis
3. Results
3.1. QSI Assays of EGCG
3.2. EGCG Inhibits P. aeruginosa Biofilm Formation
3.3. EGCG Attenuated the Production of Pyocyanin
3.4. Protease Activity of P. aeruginosa Was Inhibited by EGCG
3.5. EGCG Inhibited Elastase Activity in P. aeruginosa
3.6. Swimming and Swarming Motility of P. aeruginosa Was Inhibited by EGCG
3.7. EGCG Reduced the Production of Rhamnolipid
3.8. EGCG Decreased the Production of C4-AHL
3.9. The Expression of QS Related Genes Inhibited by EGCG
3.10. Supernatant Toxicity of P. aeruginosa in a C. elegans Model
3.11. Exogenous Supplementation of EGCG Prevents P. aeruginosa Killing of C. elegans
4. Discussion
5. Conclusions
Author Contributions
Funding
Institutional Review Board Statement
Informed Consent Statement
Data Availability Statement
Acknowledgments
Conflicts of Interest
References
- Cabrera, C.; Artacho, R.; Gimenez, R. Beneficial effects of green tea—A review. J. Am. Coll. Nutr. 2006, 25, 79–99. [Google Scholar] [CrossRef] [PubMed]
- McKay, D.L.; Blumberg, J.B. The role of tea in human health: An update. J. Am. Coll. Nutr. 2002, 21, 1–13. [Google Scholar] [CrossRef] [PubMed]
- Kaya, Z.; Yayla, M.; Cinar, I.; Atila, N.E.; Ozmen, S.; Bayraktutan, Z.; Bilici, D. Epigallocatechin-3-gallate (EGCG) exert therapeutic effect on acute inflammatory otitis media in rats. Int. J. Pediatr. Otorhinolaryngol. 2019, 124, 106–110. [Google Scholar] [CrossRef] [PubMed]
- Calland, N.; Albecka, A.; Belouzard, S.; Wychowski, C.; Duverlie, G.; Descamps, V.; Hober, D.; Dubuisson, J.; Rouille, Y.; Seron, K. (-)-Epigallocatechin-3-gallate is a new inhibitor of hepatitis C virus entry. Hepatology 2012, 55, 720–729. [Google Scholar] [CrossRef] [PubMed]
- Cerezo-Guisado, M.I.; Zur, R.; Lorenzo, M.J.; Risco, A.; Martin-Serrano, M.A.; Alvarez-Barrientos, A.; Cuenda, A.; Centeno, F. Implication of Akt, ERK1/2 and alternative p38MAPK signalling pathways in human colon cancer cell apoptosis induced by green tea EGCG. Food Chem. Toxicol. 2015, 84, 125–132. [Google Scholar] [CrossRef]
- Ramirez-Mares, M.V.; de Mejia, E.G. Comparative study of the antioxidant effect of ardisin and epigallocatechin gallate in rat hepatocytes exposed to benomyl and 1-nitropyrene. Food Chem. Toxicol. 2003, 41, 1527–1535. [Google Scholar] [CrossRef]
- Hu, Z.Q.; Zhao, W.H.; Yoda, Y.; Asano, N.; Hara, Y.; Shimamura, T. Additive, indifferent and antagonistic effects in combinations of epigallocatechin gallate with 12 non-beta-lactam antibiotics against methicillin-resistant Staphylococcus aureus. J. Antimicrob. Chemother. 2002, 50, 1051–1054. [Google Scholar] [CrossRef]
- Novy, P.; Rondevaldova, J.; Kourimska, L.; Kokoska, L. Synergistic interactions of epigallocatechin gallate and oxytetracycline against various drug resistant Staphylococcus aureus strains in vitro. Phytomedicine 2013, 20, 432–435. [Google Scholar] [CrossRef] [PubMed]
- Stapleton, P.D.; Shah, S.; Anderson, J.C.; Hara, Y.; Hamilton-Miller, J.M.; Taylor, P.W. Modulation of beta-lactam resistance in Staphylococcus aureus by catechins and gallates. Int. J. Antimicrob. Agents 2004, 23, 462–467. [Google Scholar] [CrossRef]
- Xiong, L.G.; Chen, Y.J.; Tong, J.W.; Huang, J.A.; Li, J.; Gong, Y.S.; Liu, Z.H. Tea polyphenol epigallocatechin gallate inhibits Escherichia coli by increasing endogenous oxidative stress. Food Chem. 2017, 217, 196–204. [Google Scholar] [CrossRef]
- Osterburg, A.; Gardner, J.; Hyon, S.H.; Neely, A.; Babcock, G. Highly antibiotic-resistant Acinetobacter baumannii clinical isolates are killed by the green tea polyphenol (-)-epigallocatechin-3-gallate (EGCG). Clin. Microbiol. Infect. 2009, 15, 341–346. [Google Scholar] [CrossRef] [PubMed]
- Dey, D.; Ghosh, S.; Ray, R.; Hazra, B. Polyphenolic Secondary Metabolites Synergize the Activity of Commercial Antibiotics against Clinical Isolates of beta-Lactamase-producing Klebsiella pneumoniae. Phytother. Res. 2016, 30, 272–282. [Google Scholar] [CrossRef] [PubMed]
- Bassler, B.L.; Losick, R. Bacterially speaking. Cell 2006, 125, 237–246. [Google Scholar] [CrossRef] [PubMed]
- Hense, B.A.; Schuster, M. Core principles of bacterial autoinducer systems. Microbiol. Mol. Biol. Rev. 2015, 79, 153–169. [Google Scholar] [CrossRef] [PubMed]
- Bassler, B.L.; Ng, W. Bacterial Quorum-Sensing Network Architectures. Annu. Rev. Genet. 2009, 1, 197–222. [Google Scholar]
- Mohamed, M.F.; Brezden, A.; Mohammad, H.; Chmielewski, J.; Seleem, M.N. Targeting biofilms and persisters of ESKAPE pathogens with P14KanS, a kanamycin peptide conjugate. Biochim. Biophys. Acta Gen. Subj. 2017, 1861, 848–859. [Google Scholar] [CrossRef] [PubMed]
- Werner, G.; Strommenger, B.; Witte, W. Acquired vancomycin resistance in clinically relevant pathogens. Future Microbiol. 2008, 3, 547–562. [Google Scholar] [CrossRef]
- Ruer, S.; Pinotsis, N.; Steadman, D.; Waksman, G.; Remaut, H. Virulence-targeted Antibacterials: Concept, Promise, and Susceptibility to Resistance Mechanisms. Chem. Biol. Drug Des. 2015, 86, 379–399. [Google Scholar] [CrossRef]
- Quave, C.L.; Lyles, J.T.; Kavanaugh, J.S.; Nelson, K.; Parlet, C.P.; Crosby, H.A.; Heilmann, K.P.; Horswill, A.R. Castanea sativa (European Chestnut) Leaf Extracts Rich in Ursene and Oleanene Derivatives Block Staphylococcus aureus Virulence and Pathogenesis without Detectable Resistance. PLoS ONE 2015, 10, e0136486. [Google Scholar] [CrossRef]
- LaSarre, B.; Federle, M.J. Exploiting quorum sensing to confuse bacterial pathogens. Microbiol. Mol. Biol. Rev. 2013, 77, 73–111. [Google Scholar] [CrossRef]
- Moradali, M.F.; Ghods, S.; Rehm, B.H. Pseudomonas aeruginosa Lifestyle: A Paradigm for Adaptation, Survival, and Persistence. Front. Cell Infect. Microbiol. 2017, 7, 39. [Google Scholar] [CrossRef] [PubMed]
- Hogardt, M.; Heesemann, J. Microevolution of Pseudomonas aeruginosa to a chronic pathogen of the cystic fibrosis lung. Curr. Top. Microbiol. Immunol. 2013, 358, 91–118. [Google Scholar] [PubMed]
- Martin, L.W.; Robson, C.L.; Watts, A.M.; Gray, A.R.; Wainwright, C.E.; Bell, S.C.; Ramsay, K.A.; Kidd, T.J.; Reid, D.W.; Brockway, B.; et al. Expression ofPseudomonas aeruginosaAntibiotic Resistance Genes Varies Greatly during Infections in Cystic Fibrosis Patients. Antimicrob. Agents Chemother. 2018, 62. [Google Scholar] [CrossRef] [PubMed]
- Emerson, J.; Rosenfeld, M.; McNamara, S.; Ramsey, B.; Gibson, R.L. Pseudomonas aeruginosa and other predictors of mortality and morbidity in young children with cystic fibrosis. Pediatr. Pulmonol. 2002, 34, 91–100. [Google Scholar] [CrossRef] [PubMed]
- Batool, N.; Yoon, S.; Imdad, S.; Kong, M.; Kim, H.; Ryu, S.; Lee, J.H.; Chaurasia, A.K.; Kim, K.K. An Antibacterial Nanorobotic Approach for the Specific Targeting and Removal of Multiple Drug-Resistant Staphylococcus aureus. Small 2021, 2100257. [Google Scholar] [CrossRef] [PubMed]
- Vila, J.; Moreno-Morales, J.; Balleste-Delpierre, C. Current landscape in the discovery of novel antibacterial agents. Clin. Microbiol. Infect. 2020, 26, 596–603. [Google Scholar] [CrossRef]
- Saeed, A.; Bosch, A.; Bettiol, M.; González, D.L.N.; Erben, M.F.; Lamberti, Y. Novel Guanidine Compound against Multidrug-Resistant Cystic Fibrosis-Associated Bacterial Species. Molecules 2018, 23, 1158. [Google Scholar] [CrossRef]
- Santajit, S.; Indrawattana, N. Mechanisms of Antimicrobial Resistance in ESKAPE Pathogens. Biomed. Res. Int. 2016, 2016, 2475067. [Google Scholar] [CrossRef]
- Aeschlimann, J.R. The role of multidrug efflux pumps in the antibiotic resistance of Pseudomonas aeruginosa and other gram-negative bacteria. Insights from the Society of Infectious Diseases Pharmacists. Pharmacotherapy 2003, 23, 916–924. [Google Scholar] [CrossRef]
- Laudy, A.E.; Mrowka, A.; Krajewska, J.; Tyski, S. The Influence of Efflux Pump Inhibitors on the Activity of Non-Antibiotic NSAIDS against Gram-Negative Rods. PLoS ONE 2016, 11, e0147131. [Google Scholar] [CrossRef]
- Ahmed, M.N.; Porse, A.; Sommer, M.; Hoiby, N.; Ciofu, O. Evolution of Antibiotic Resistance in Biofilm and Planktonic Pseudomonas aeruginosa Populations Exposed to Subinhibitory Levels of Ciprofloxacin. Antimicrob. Agents Chemother. 2018, 62, 8. [Google Scholar] [CrossRef] [PubMed]
- Soren, O.; Rineh, A.; Silva, D.G.; Cai, Y.; Howlin, R.P.; Allan, R.N.; Feelisch, M.; Davies, J.C.; Connett, G.J.; Faust, S.N.; et al. Cephalosporin nitric oxide-donor prodrug DEA-C3D disperses biofilms formed by clinical cystic fibrosis isolates of Pseudomonas aeruginosa. J. Antimicrob. Chemother. 2020, 75, 117–125. [Google Scholar] [CrossRef] [PubMed]
- Lee, J.; Zhang, L. The hierarchy quorum sensing network in Pseudomonas aeruginosa. Protein Cell 2015, 6, 26–41. [Google Scholar] [CrossRef] [PubMed]
- Williams, P.; Camara, M. Quorum sensing and environmental adaptation in Pseudomonas aeruginosa: A tale of regulatory networks and multifunctional signal molecules. Curr. Opin. Microbiol. 2009, 12, 182–191. [Google Scholar] [CrossRef] [PubMed]
- Oliveira, B.D.; Rodrigues, A.C.; Cardoso, B.M.I.; Ramos, A.L.C.C.; Bertoldi, M.C.; Taylor, J.G.; da Cunha, L.R.; Pinto, U.M. Antioxidant, antimicrobial and anti-quorum sensing activities of Rubus rosaefolius phenolic extract. Ind. Crop. Prod. 2016, 84, 59–66. [Google Scholar] [CrossRef]
- Adonizio, A.L.; Downum, K.; Bennett, B.C.; Mathee, K. Anti-quorum sensing activity of medicinal plants in southern Florida. J. Ethnopharmacol. 2006, 105, 427–435. [Google Scholar] [CrossRef] [PubMed]
- Packiavathy, I.A.; Priya, S.; Pandian, S.K.; Ravi, A.V. Inhibition of biofilm development of uropathogens by curcumin—An anti-quorum sensing agent from Curcuma longa. Food Chem. 2014, 148, 453–460. [Google Scholar] [CrossRef] [PubMed]
- Husain, F.M.; Ahmad, I.; Al-Thubiani, A.S.; Abulreesh, H.H.; AlHazza, I.M.; Aqil, F. Leaf Extracts of Mangifera indica L. Inhibit Quorum Sensing—Regulated Production of Virulence Factors and Biofilm in Test Bacteria. Front. Microbiol. 2017, 8, 727. [Google Scholar] [CrossRef] [PubMed]
- Chatterjee, M.; D’Morris, S.; Paul, V.; Warrier, S.; Vasudevan, A.K.; Vanuopadath, M.; Nair, S.S.; Paul-Prasanth, B.; Mohan, C.G.; Biswas, R. Mechanistic understanding of Phenyllactic acid mediated inhibition of quorum sensing and biofilm development in Pseudomonas aeruginosa. Appl. Microbiol. Biotechnol. 2017, 101, 8223–8236. [Google Scholar] [CrossRef]
- Chen, B.M.; Yu, J.L.; Liu, G.X.; Hu, L.Y.; Hua, Y. The quantitive analysis of sequential development of biofilm spatial structure of P.aeruginosa tagged with green fluorescence protein. Chin. J. Antibiot. 2008, 33, 540–543. [Google Scholar]
- Dai, L.; Wu, T.Q.; Xiong, Y.S.; Ni, H.B.; Ding, Y.; Zhang, W.C.; Chu, S.P.; Ju, S.Q.; Yu, J. Ibuprofen-mediated potential inhibition of biofilm development and quorum sensing in Pseudomonas aeruginosa. Life Sci. 2019, 237, 116947. [Google Scholar] [CrossRef]
- Welsh, M.A.; Eibergen, N.R.; Moore, J.D.; Blackwell, H.E. Small molecule disruption of quorum sensing cross-regulation in pseudomonas aeruginosa causes major and unexpected alterations to virulence phenotypes. J. Am. Chem. Soc. 2015, 137, 1510–1519. [Google Scholar] [CrossRef]
- Rashmi, M.; Meena, H.; Meena, C.; Kushveer, J.S.; Busi, S.; Murali, A.; Sarma, V.V. Anti-quorum sensing and antibiofilm potential of Alternaria alternata, a foliar endophyte of Carica papaya, evidenced by QS assays and in-silico analysis. Fungal Biol. 2018, 122, 998–1012. [Google Scholar] [CrossRef] [PubMed]
- Yin, H.; Deng, Y.; Wang, H.; Liu, W.; Zhuang, X.; Chu, W. Tea polyphenols as an antivirulence compound Disrupt Quorum-Sensing Regulated Pathogenicity of Pseudomonas aeruginosa. Sci. Rep. 2015, 5, 16158. [Google Scholar] [CrossRef] [PubMed]
- Jack, A.A.; Khan, S.; Powell, L.C.; Pritchard, M.F.; Beck, K.; Sadh, H.; Sutton, L.; Cavaliere, A.; Florance, H.; Rye, P.D.; et al. Alginate Oligosaccharide-Induced Modification of the lasI-lasR and rhlI-rhlR Quorum-Sensing Systems in Pseudomonas aeruginosa. Antimicrob. Agents Chemother. 2018, 62, 5. [Google Scholar] [CrossRef] [PubMed]
- Sarabhai, S.; Sharma, P.; Capalash, N. Ellagic acid derivatives from Terminalia chebula Retz. downregulate the expression of quorum sensing genes to attenuate Pseudomonas aeruginosa PAO1 virulence. PLoS ONE 2013, 8, e53441. [Google Scholar] [CrossRef] [PubMed]
- Mulcahy, L.R.; Isabella, V.M.; Lewis, K. Pseudomonas aeruginosa biofilms in disease. Microb. Ecol. 2014, 68, 1–12. [Google Scholar] [CrossRef]
- Maurice, N.M.; Bedi, B.; Sadikot, R.T. Pseudomonas aeruginosa Biofilms: Host Response and Clinical Implications in Lung Infections. Am. J. Respir. Cell Mol. Biol. 2018, 58, 428–439. [Google Scholar] [CrossRef]
- Perez-Perez, M.; Jorge, P.; Perez, R.G.; Pereira, M.O.; Lourenco, A. Quorum sensing inhibition in Pseudomonas aeruginosa biofilms: New insights through network mining. Biofouling 2017, 33, 128–142. [Google Scholar] [CrossRef]
- McCready, A.R.; Paczkowski, J.E.; Cong, J.P.; Bassler, B.L. An autoinducer-independent RhlR quorum-sensing receptor enables analysis of RhlR regulation. PLoS Pathog. 2019, 15, e1007820. [Google Scholar] [CrossRef]
- Caldwell, C.C.; Chen, Y.; Goetzmann, H.S.; Hao, Y.; Borchers, M.T.; Hassett, D.J.; Young, L.R.; Mavrodi, D.; Thomashow, L.; Lau, G.W. Pseudomonas aeruginosa exotoxin pyocyanin causes cystic fibrosis airway pathogenesis. Am. J. Pathol. 2009, 175, 2473–2488. [Google Scholar] [CrossRef] [PubMed]
- Starkey, M.; Rahme, L.G. Modeling Pseudomonas aeruginosa pathogenesis in plant hosts. Nat. Protoc. 2009, 4, 117–124. [Google Scholar] [CrossRef] [PubMed]
- Rahme, L.G.; Stevens, E.J.; Wolfort, S.F.; Shao, J.; Tompkins, R.G.; Ausubel, F.M. Common virulence factors for bacterial pathogenicity in plants and animals. Science 1995, 268, 1899–1902. [Google Scholar] [CrossRef] [PubMed]
- Strateva, T.; Mitov, I. Contribution of an arsenal of virulence factors to pathogenesis of Pseudomonas aeruginosa infections. Ann. Microbiol. 2011, 4, 717–732. [Google Scholar] [CrossRef]
- Stehling, E.G.; Silveira, W.D.D.; Leite, D.D.S. Study of biological characteristics of Pseudomonas aeruginosa strains isolated from patients with cystic fibrosis and from patients with extra-pulmonary infections. Braz. J. Infect. Dis. Off. Publ. Braz. Soc. Infect. Dis. 2008, 1, 86–88. [Google Scholar] [CrossRef]
- O'Toole, G.A.; Kolter, R. Flagellar and twitching motility are necessary for Pseudomonas aeruginosa biofilm development. Mol. Microbiol. 1998, 30, 295–304. [Google Scholar] [CrossRef]
- Shrout, J.D.; Chopp, D.L.; Just, C.L.; Hentzer, M.; Givskov, M.; Parsek, M.R. The impact of quorum sensing and swarming motility on Pseudomonas aeruginosa biofilm formation is nutritionally conditional. Mol. Microbiol. 2006, 62, 1264–1277. [Google Scholar] [CrossRef] [PubMed]
- O'May, C.; Tufenkji, N. The swarming motility of Pseudomonas aeruginosa is blocked by cranberry proanthocyanidins and other tannin-containing materials. Appl Env. Microbiol. 2011, 77, 3061–3067. [Google Scholar] [CrossRef]
- Utari, P.D.; Quax, W.J. Caenorhabditis elegans reveals novel Pseudomonas aeruginosa virulence mechanism. Trends Microbiol. 2013, 21, 315–316. [Google Scholar] [CrossRef]
- Jeon, J.; Kim, J.H.; Lee, C.K.; Oh, C.H.; Song, H.J. The Antimicrobial Activity of (-)-Epigallocatehin-3-Gallate and Green Tea Extracts against Pseudomonas aeruginosa and Escherichia coli Isolated from Skin Wounds. Ann. Derm. 2014, 26, 564–569. [Google Scholar] [CrossRef]
- Lahiri, S.S. Bacterial toxins—An overview. J. Nat. Toxins 2000, 9, 381–408. [Google Scholar] [PubMed]
- Stenvang, M.; Dueholm, M.S.; Vad, B.S.; Seviour, T.; Zeng, G.; Geifman-Shochat, S.; Sondergaard, M.T.; Christiansen, G.; Meyer, R.L.; Kjelleberg, S.; et al. Epigallocatechin Gallate Remodels Overexpressed Functional Amyloids in Pseudomonas aeruginosa and Increases Biofilm Susceptibility to Antibiotic Treatment. J. Biol. Chem. 2016, 291, 26540–26553. [Google Scholar] [CrossRef] [PubMed]
- Bieschke, J.; Russ, J.; Friedrich, R.P.; Ehrnhoefer, D.E.; Wobst, H.; Neugebauer, K.; Wanker, E.E. EGCG remodels mature alpha-synuclein and amyloid-beta fibrils and reduces cellular toxicity. Proc. Natl. Acad. Sci. USA 2010, 107, 7710–7715. [Google Scholar] [CrossRef] [PubMed]
- Serra, D.O.; Mika, F.; Richter, A.M.; Hengge, R. The green tea polyphenol EGCG inhibits E. coli biofilm formation by impairing amyloid curli fibre assembly and downregulating the biofilm regulator CsgD via the sigma(E) -dependent sRNA RybB. Mol. Microbiol. 2016, 101, 136–151. [Google Scholar] [CrossRef]
- Silva, L.N.; Zimmer, K.R.; Macedo, A.J.; Trentin, D.S. Plant Natural Products Targeting Bacterial Virulence Factors. Chem. Rev. 2016, 116, 9162–9236. [Google Scholar] [CrossRef]
- Vandeputte, O.M.; Kiendrebeogo, M.; Rajaonson, S.; Diallo, B.; Mol, A.; El, J.M.; Baucher, M. Identification of catechin as one of the flavonoids from Combretum albiflorum bark extract that reduces the production of quorum-sensing-controlled virulence factors in Pseudomonas aeruginosa PAO1. Appl Env. Microbiol. 2010, 76, 243–253. [Google Scholar] [CrossRef] [PubMed]
- Petrova, O.E.; Schurr, J.R.; Schurr, M.J.; Sauer, K. The novel Pseudomonas aeruginosa two-component regulator BfmR controls bacteriophage-mediated lysis and DNA release during biofilm development through PhdA. Mol. Microbiol. 2011, 81, 767–783. [Google Scholar] [CrossRef] [PubMed]
- Pamp, S.J.; Tolker-Nielsen, T. Multiple roles of biosurfactants in structural biofilm development by Pseudomonas aeruginosa. J. Bacteriol. 2007, 189, 2531–2539. [Google Scholar] [CrossRef]
- Wang, H.; Chu, W.; Ye, C.; Gaeta, B.; Tao, H.; Wang, M.; Qiu, Z. Chlorogenic acid attenuates virulence factors and pathogenicity of Pseudomonas aeruginosa by regulating quorum sensing. Appl. Microbiol. Biotechnol. 2019, 103, 903–915. [Google Scholar] [CrossRef] [PubMed]
- Wang, S.; Yu, S.; Zhang, Z.; Wei, Q.; Yan, L.; Ai, G.; Liu, H.; Ma, L.Z. Coordination of swarming motility, biosurfactant synthesis, and biofilm matrix exopolysaccharide production in Pseudomonas aeruginosa. Appl. Env. Microbiol. 2014, 80, 6724–6732. [Google Scholar] [CrossRef]
- Chatterjee, M.; Anju, C.P.; Biswas, L.; Anil Kumar, V.; Gopi Mohan, C.; Biswas, R. Antibiotic resistance in Pseudomonas aeruginosa and alternative therapeutic options. Int. J. Med. Microbiol. 2016, 1, 48–58. [Google Scholar] [CrossRef] [PubMed]
- Bandara, M.B.; Zhu, H.; Sankaridurg, P.R.; Willcox, M.D. Salicylic acid reduces the production of several potential virulence factors of Pseudomonas aeruginosa associated with microbial keratitis. Invest. Ophthalmol. Vis. Sci. 2006, 47, 4453–4460. [Google Scholar] [CrossRef]
- Ahmed, S.; Rudden, M.; Smyth, T.J.; Dooley, J.; Marchant, R.; Banat, I.M. Natural quorum sensing inhibitors effectively downregulate gene expression of Pseudomonas aeruginosa virulence factors. Appl. Microbiol. Biotechnol. 2019, 103, 3521–3535. [Google Scholar] [CrossRef] [PubMed]
- Schuster, M.; Greenberg, E.P. A network of networks: Quorum-sensing gene regulation in Pseudomonas aeruginosa. Int. J. Med. Microbiol. 2006, 296, 73–81. [Google Scholar] [CrossRef] [PubMed]
- Patel, P.; Joshi, C.; Kothari, V. The Anti-infective Potential of Hydroalcoholic Extract of Phyllanthus emblica Seeds Against Selected Human-pathogenic Bacteria. Infect. Disord Drug Targets 2020, 20, 672–692. [Google Scholar] [CrossRef] [PubMed]
- Luo, J.; Dong, B.; Wang, K.; Cai, S.; Liu, T.; Cheng, X.; Lei, D.; Chen, Y.; Li, Y.; Kong, J.; et al. Baicalin inhibits biofilm formation, attenuates the quorum sensing-controlled virulence and enhances Pseudomonas aeruginosa clearance in a mouse peritoneal implant infection model. PLoS ONE 2017, 12, e0176883. [Google Scholar] [CrossRef] [PubMed]

| Target Name | Type | Primer Sequence |
|---|---|---|
| lasI | Fw | CGCACATCTGGGAACTCA |
| Rev | CGGCACGGATCATCATCT | |
| lasR | Fw | CTGTGGATGCTCAAGGACTAC |
| Rev | AACTGGTCTTGCCGATGG | |
| rhlI | Fw | GTAGCGGGTTTGCGGATG |
| Rev | CGGCATCAGGTCTTCATCG | |
| rhlR | Fw | GCCAGCGTCTTGTTCGG |
| Rev | CGGTCTGCCTGAGCCATC | |
| pqsA | Fw | GACCGGCTGTATTCGATTC |
| Rev | GCTGAACCAGGGAAAGAAC | |
| pqsR | Fw | CTGATCTGCCGGTAATTGG |
| Rev | ATCGACGAGGAACTGAAGA | |
| phzM | Fw | ACGGCTGTGGCGGTTTA |
| Rev | CCGTGACCGTCGCATT | |
| lasA | Fw | CTGTGGATGCTCAAGGACTAC |
| Rev | AACTGGTCTTGCCGATGG | |
| lasB | Fw | AACCGTGCGTTCTACCTGTT |
| Rev | CGGTCCAGTAGTAGCGGTTG | |
| phzA | Fw | AACGGTCAGCGGTACAGGGAAAC |
| Rev | ACGAACAGGCTGTGCCGCTGTAAC | |
| phzH | Fw | GCTCATCGACAATGCCGAACT |
| Rev | GCGGATCTCGCCGAACATCAG | |
| phzS | Fw | CCGAAGGCAAGTCGCTGGTGA |
| Rev | GGTCCCAGTCGGCGAAGAACG | |
| RhlA | Fw | TGGCCGAACATTTCAACGT |
| Rev | GATTTCCACCTCGTCGTCCTT | |
| RhlC | Fw | GCCATCCATCTCGACGGAC |
| Rev | CGCAGGCTGTATTCGGTG | |
| PvdQ | Fw | GCCGAGGAGATCGTCACC |
| Rev | CAGGCGTAGAAGATGTCGGA |
Publisher’s Note: MDPI stays neutral with regard to jurisdictional claims in published maps and institutional affiliations. |
© 2021 by the authors. Licensee MDPI, Basel, Switzerland. This article is an open access article distributed under the terms and conditions of the Creative Commons Attribution (CC BY) license (https://creativecommons.org/licenses/by/4.0/).
Share and Cite
Hao, S.; Yang, D.; Zhao, L.; Shi, F.; Ye, G.; Fu, H.; Lin, J.; Guo, H.; He, R.; Li, J.; et al. EGCG-Mediated Potential Inhibition of Biofilm Development and Quorum Sensing in Pseudomonas aeruginosa. Int. J. Mol. Sci. 2021, 22, 4946. https://doi.org/10.3390/ijms22094946
Hao S, Yang D, Zhao L, Shi F, Ye G, Fu H, Lin J, Guo H, He R, Li J, et al. EGCG-Mediated Potential Inhibition of Biofilm Development and Quorum Sensing in Pseudomonas aeruginosa. International Journal of Molecular Sciences. 2021; 22(9):4946. https://doi.org/10.3390/ijms22094946
Chicago/Turabian StyleHao, Suqi, Dan Yang, Ling Zhao, Fei Shi, Gang Ye, Hualin Fu, Juchun Lin, Hongrui Guo, Ran He, Jianlong Li, and et al. 2021. "EGCG-Mediated Potential Inhibition of Biofilm Development and Quorum Sensing in Pseudomonas aeruginosa" International Journal of Molecular Sciences 22, no. 9: 4946. https://doi.org/10.3390/ijms22094946
APA StyleHao, S., Yang, D., Zhao, L., Shi, F., Ye, G., Fu, H., Lin, J., Guo, H., He, R., Li, J., Chen, H., Khan, M. F., Li, Y., & Tang, H. (2021). EGCG-Mediated Potential Inhibition of Biofilm Development and Quorum Sensing in Pseudomonas aeruginosa. International Journal of Molecular Sciences, 22(9), 4946. https://doi.org/10.3390/ijms22094946

